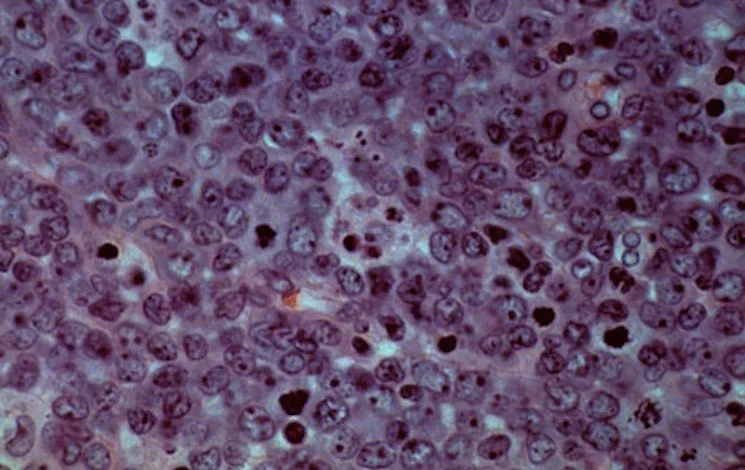
Allogene’s CAR-T could delay or prevent cancer recurrence

Allogene’s CAR-T could delay or prevent cancer recurrence
Allogene Therapeutics said Monday that its off-the-shelf CAR-T treatment eliminated residual cancer cells in patients with B-cell lymphoma three times better than standard care — achieving the interim goal of an ongoing Phase 3 clinical trial.
While still preliminary, the new data bolster Allogene’s efforts to develop an easily administered cell therapy that, for the first time, could delay or prevent the recurrence of cancer in patients with a high risk of lymphoma relapse at the end of first-line treatment.
STAT Plus: Some blood cancer patients see remission with Allogene’s off-the-shelf CAR-T cells, early data show
In the interim analysis, 58% of patients treated with the Allogene CAR-T, called cema-cel, achieved minimal residual disease, or MRD, negativity compared to 16% of patients who were observed but not treated.
STAT+ Exclusive Story
Already have an account? Log in
This article is exclusive to STAT+ subscribers
Unlock this article — plus daily coverage and analysis of the biotech sector — by subscribing to STAT+.
Already have an account? Log in
Individual plans
Group plans
View All Plans
To read the rest of this story subscribe to STAT+.
Subscribe



